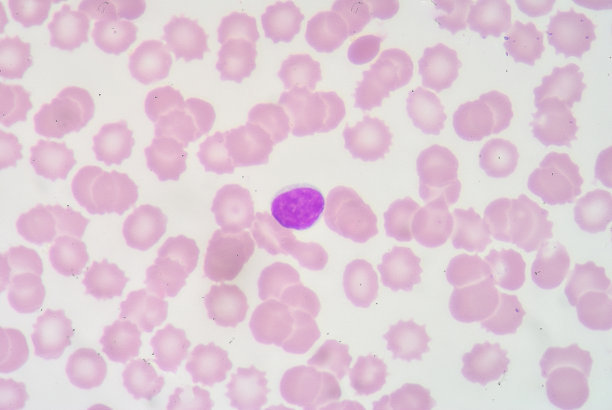
白细胞高说明什么

最佳回答
本文由作者推荐
简要回答
血常规血白细胞偏高是指在血常规的检测当中,白细胞的指数偏高这一现象经常出现,但是你知道白细胞增高意味着什么吗,我们一起看看吧

白细胞升高一般提示是细菌感染,当然还需要结合患者的临床症状,以及其他的炎性指标等检查结果进行综合的判断。
详细内容
详细内容
- 01
白细胞升高意味着身体内有炎症了。

- 02
白细胞升高一般提示是细菌感染,当然我们不能用这个单一指标来判断,还需要进行综合的判断。

- 03
白细胞升高也有可能是病毒感染,具体还得听医生的建议。
- 04
还有一小部分可能是特殊疾病引起的,例如白血病。

- 05
总而言之,白细胞升高是有很多的原因的,我们不能从单一方面来进行判断。

广告位
点击排行
- 2 排行
- 3 排行
- 4 排行
- 5 排行
- 6 排行
- 7 排行
- 8 排行
- 9 排行
- 10 排行
热点追踪
广告位


